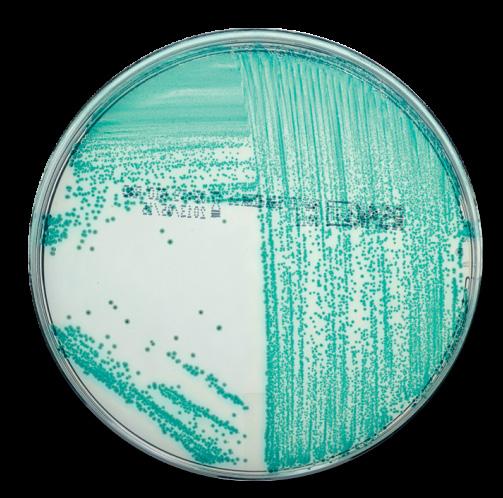

SCANDIAGNOSTIC S
Sida
Sida 4-5
Sida 6-7


![]()
Sida
Sida 4-5
Sida 6-7

Vid användning av ett PIF-supplement är det möjligt att anrika upp till 375g (samlingsprov), vilket kan vara relevant i förhållande till exempelvis amerikansk lagstiftning (FDA-BAM) och samtidigt nöja sig med en utspädning på 1:4.
För ett prov på 375 g måste 3375 ml BPW tillsättas enligt standardprotokollet. Vid användning av PIF- supplement tillsätts 1125 ml BPW och 150 μl rehydrerat PIF-supplement för samma provmängd. Så en besparing på 2250 ml BPW per prov.
Försök själv att räkna ut hur mycket du kan spara per dag –eller per år.
PIF- supplement kan användas för prover med hög bakgrundsflora, till exempel mjölksyrabakterier, bifidobakterier och andra grampositiva bakterier.
PIF- supplement används tillsammans med buffrat peptonvatten (BPW) för odling av Enterobacteriaceae, Salmonella spp. och Cronobacter spp.
Den är särskilt lämplig för detektion av Salmonella spp. och Cronobacter spp. i modersmjölksersättning och barnmat med eller utan probiotika, ingredienser för dessa produkter, och för miljöprover från produktionen.

Kortfattat:
För gemensam anrikning för påvisning av Enterobacteriaceae, Cronobacter och Salmonella
Stor provstorlek (upp till 375 g)
• Utspädningsförhållande 1:4 istället för 1:10
• Afnor-validerade applikationer för både iQ-Check Real-Time PCR-lösningar och
Se en video om hur du använder PIF-supplementet här:


Relevanta kit från Bio-Rad för analys av Enterobacteriaceae, Salmonella och Cronobacter: iQ-Check Enterobacteriaceae PCR Kit
Detta kit är utformat för att upptäcka DNA-sekvenser som är specifika för Enterobacteriaceae i modersmjölksersättning, relaterade råvaror och miljöprover. Den kan också användas parallellt med andra iQ-Check kit för Cronobacter och Salmonella iQ-Check Salmonella II PCR Kit
Detta kit är utformat för snabb och exakt detektion av Salmonella spp. i olika livsmedelsprover
RAPID'Salmonella Agar
Detta högkänsliga medium har utvecklats för påvisande av Salmonella spp. i livsmedel och djur. Resultat kan uppnås inom 48 timmar.
RAPID'Sakazakii Agar
Detta selektiva kromogena medium är speciellt avsett för detektion av Cronobacter spp. (tidigare känd som Enterobacter sakazakii). Den är idealisk för användning inom livsmedelsindustrin och ger resultat inom 24-48 timmar.
Dessa medier och PCR-kit är kända för sin höga specificitet och tillförlitlighet, vilket gör dem idealiska för användning i både livsmedels- och miljöprover.

Fakta
Salmonella sprids ofta via förorenade livsmedel och vatten. Vanliga infektionskällor är fjäderfä, fläsk, nötkött, ägg, opastöriserad mjölk och råa grönsaker. Symtom på en salmonellainfektion kan vara diarré, buksmärtor, illamående, kräkningar och feber. I allvarliga fall kan infektionen leda till uttorkning och kräva sjukhusvård.
Cronobacter (tidigare Enterobacter sakazakii) är ett släkte gramnegativa bakterier som kan orsaka allvarliga infektioner, särskilt hos spädbarn. Infektioner med Cronobacter kan leda till hjärnhinneinflammation och blodförgiftning hos spädbarn under 12 månader, och de är särskilt farliga för nyfödda och spädbarn med försvagat immunförsvar. Även om infektioner är sällsynta kan de vara dödliga.



Det är viktigt att analysera för Enterobacteriaceae i vissa livsmedel av flera skäl:
1. Hygienindikator: Enterobacteriaceae fungerar som en indikator på hygiennivån under livsmedelsproduktion och bearbetning. Höga nivåer kan tyda på dålig hygien eller kontaminering under produktionen.
2. Kvalitetskontroll: Regelbundna tester för Enterobacteriaceae hjälper till att säkerställa att livsmedlet uppfyller de nödvändiga kvalitetsstandarderna och är säkert för konsumenten.
3. Förebyggande av sjukdomar: Genom att övervaka och kontrollera nivåerna av Enterobacteriaceae kan livsmedelstillverkare minska risken för livsmedelsburna sjukdomar och skydda konsumenternas hälsa.
4. Livsmedelssäkerhet: Även om Enterobacteriaceae i sig inte nödvändigtvis är patogena, kan deras förekomst tyda på att patogena bakterier, såsom Salmonella och E. coli, också kan förekomma.
Camilla Larsson camilla.larsson@scandiagnostics.se
Det är nästan bara fantasin som sätter gränser
När vi pratar om detekterbar plast är det nästan bara fantasin som sätter gränser för vilka produkter som finns tillgängliga. Och naturligtvis har vi många fler detekterbara produkter som kan hjälpa dig att producera säkra livsmedel.
Kontakta oss därför gärna om du har ett speciellt önskemål, så gör vi allt för att hjälpa dig.
Kom ihåg att testa din metalldetektor!
För att vara säker på att du kan lita på de resultat som din metalldetektor ger är det viktigt att den är testad så att den alltid ger en korrekt bild av produktionen.
Därför erbjuder vi ett brett sortiment av olika produkter för provning och kalibrering av metalldetektorer och röntgenapparater, Fe, non-Fe och SS316 i olika storlekar.

Visuell spårning med godkänd HACCP-färgkodning.
Vi kan erbjuda färgkodad utrustning för att särskilja funktionen hos de olika objekten och till exempel vilken avdelning de tillhör.
Denna lösning möjliggör visuell spårning av en eventuell kontaminering samtidigt som risken för korskontaminering minskar.
Här är en översikt över vilka färger den detekterbara plasten finns i:
Den blå färgen används ofta inom livsmedelsindustrin. Detta utnyttjar det faktum att färgen blå inte förekommer i naturliga livsmedel. Låt oss hjälpa dig att göra din produktion ännu säkrare genom att utrusta din produktion med färgkodade verktyg i en av de många tillgängliga färgerna.
Vissa gillar mest de smala, andra föredrar de tjocka och många gillar de däremellan.
Naturligtvis är det detekterbara pennor som avses! Vi ger dig möjlighet att välja mellan ett brett utbud av olika bläck- och tuschpennor.
Dessutom erbjuder vi serienummerering av dina detekterbara pennor utan extra kostnad. Det är även möjligt att få en logotyp till ett lågt pris.
Här får ni en liten inblick i vårt breda sortiment.
Detekterbar kulspetspenna med en fyrkantig del.
Med den fyrkantiga designen undviker du att pennan rullar på en sluttande yta. Finns i en mängd olika färger, vilket gör färgkodning möjlig och med/utan clips.

Påvisbara. Finns med rund eller platt spets i flera färger.




Påvisbara. Kan skriva på de flesta ytor.

Infällbar penna med färg-refill
Samma funktioner som one-piece pennan. Den är metalldetekterbar och denna penna kan även detekteras i röntgen. Många färger.
Utbytbar färg-refill.
Erik Björkegren erik.bjorkegren@scandiagnostics.se Tlf: 031-792 20 25


RIDASCREEN®EASY Allergen ELISA-kitet är en helt ny lösning för livsmedelsanalys som gör det möjligt att detektera allergener med hög precision och tillförlitlighet. Dessa testkit är utformade för att vara användarvänliga och effektiva, vilket gör dem idealiska för både laboratorier och livsmedelstillverkare som vill säkerställa att deras produkter är fria från oönskade allergener.
RIDASCREEN®EASY Allergen ELISA-kit för de olika allergenerna enligt lagstiftningen kommer att valideras kontinuerligt och bli en del av portföljen. Just nu finns kit för gluten, senap och kräftdjur.
RIDASCREEN®EASY Allergen ELISA-kit är utformade så att samma extraktion kan användas för flera olika ELISA-allergenanalyser, vilket sparar tid och resurser.


Kvantitativ analys av allergenrester i livsmedel.

Enkel extraktion med EASY extraction-tablett.




Den samma extraktion för de flesta prover. Resultat i mg protein/kg.
Testkit med spike-lösning och färdiga reagenser.
Validerad med provmatris som följer AOAC riktlinjer.







RIDASCREEN® FAST Gliadin 0.50 mg / kg gliadin 5 mg/kg gliadin
RIDASCREEN®
RIDASCREEN® FAST Mustard 0,1 mg/kg senap 0,5 mg/kg senap
RIDASCREEN® EASY Mustard 0,02 mg/ kg senneps protein 0,2 mg/kg senneps protein
RIDASCREEN® EASY Crustacean 0,15 mg/kg protein 2,5 mg/kg krebsdyrprotein








brunnar Cocktail/cocktal
brunnar Tablett
Mjölkprotein är ett viktigt protein som finns naturligt i däggdjursmjölk. Sammansättningen av mjölkprotein kan variera beroende på faktorer som djurart, ras, foder och laktationsstadium, men totalt sett består det av två huvudtyper: kasein och vassleprotein.
Kasein:
• Utgör den största delen av mjölkproteinet (ca 80%).
• Består huvudsakligen av fyra olika typer: as1-kasein, as2-kasein, ß-kasein och ĸ-kasein.
• Dessa kaseiner binder samman i komplexa strukturer som kallas miceller, som ger mjölken dess distinkta vita färg och hjälper till att stabilisera kalciumet i mjölken.
• Kasein kännetecknas av att det koagulerar i magen, vilket gör det till en långsam proteinkälla.
Valleprotein:
• Utgör den mindre delen av mjölkproteinet (ca 20%).
• Består främst av ß-laktoglobulin, a-laktalbumin, bovint serumalbumin (BSA) och immunglobuliner.
• Vassleprotein kännetecknas av att det är lättsmält och absorberas snabbt i kroppen.
• Den har ett högt biologiskt värde, vilket innebär att den innehåller alla essentiella aminosyror som kroppen behöver.
Funktioner och näringsmässig betydelse:
• Mjölkprotein spelar en viktig roll för tillväxt och utveckling, eftersom det ger essentiella aminosyror som är byggstenarna för muskler, vävnader och enzymer.

• Det är också viktigt för immunförsvaret, eftersom det innehåller immunglobuliner som kan hjälpa till att bekämpa infektioner.
• Mjölkprotein har visat sig ha en positiv effekt på muskeluppbyggnad och återhämtning efter träning, vilket gör det populärt bland idrottare.
• Dessutom kan mjölkprotein bidra till viktkontroll, eftersom det kan öka mättnadskänslan och minska aptiten.
Märkning av mjölkprotein:
Enligt EU:s regler om livsmedelsinformation måste alla ingredienser som finns med på listan över de 14 vanligaste allergenerna, inklusive mjölk, anges tydligt på livsmedelsetiketten. Det innebär att mjölkprotein ska markeras i ingredienslistan, till exempel genom fetstil, kursiv stil eller annan visuell markering.
Dessutom måste det tydligt anges om en produkt innehåller mjölkprotein, även om det inte är en direkt ingrediens, men t.ex. har kommit in i produkten som en (oönskad) del av en ingrediens, korskontaminering eller av misstag vid rengöring.
I så fall måste det stå "Kan innehålla spår av
Det är nu möjligt att förregistrera ditt instrument online för verifiering, kalibrering eller service.
Läs mycket mer på vår hemsida

Scandinavian Diagnostics AB Norra Ågaten 10 41664 Göteborg Sverige
Tlf: 031-792 2020
Mail: order@scandiagnostics.se





